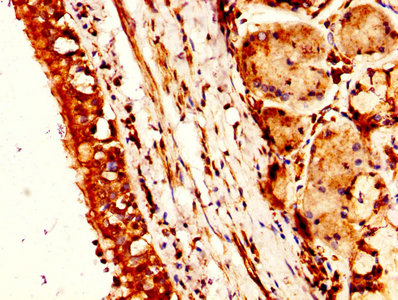

NTS Antibody
-
中文名稱:NTS兔多克隆抗體
-
貨號:CSB-PA016136HA01HU
-
規(guī)格:¥440
-
圖片:
-
Western blot
All lanes: NTS antibody at 2µg/ml + Mouse small intestine tissue
Secondary
Goat polyclonal to rabbit IgG at 1/10000 dilution
Predicted band size: 20 kDa
Observed band size: 20 kDa -
IHC image of CSB-PA016136HA01HU diluted at 1:300 and staining in paraffin-embedded human lung cancer performed on a Leica BondTM system. After dewaxing and hydration, antigen retrieval was mediated by high pressure in a citrate buffer (pH 6.0). Section was blocked with 10% normal goat serum 30min at RT. Then primary antibody (1% BSA) was incubated at 4°C overnight. The primary is detected by a biotinylated secondary antibody and visualized using an HRP conjugated SP system.
-
-
其他:
產(chǎn)品詳情
-
產(chǎn)品名稱:Rabbit anti-Homo sapiens (Human) NTS Polyclonal antibody
-
Uniprot No.:
-
基因名:NTS
-
別名:Human proneurotensin antibody; Large neuromedin N antibody; Neuromedin N preproprotein antibody; Neurotensin/neuromedin N antibody; NEUT_HUMAN antibody; NMN 125 antibody; NmN antibody; NmN-125 antibody; NN antibody; NT antibody; NT/N antibody; NTRH antibody; NTS antibody; NTS1 antibody; Pro neurotensin/neuromedin antibody; Proneuromedin N mRNA antibody; Tail peptide antibody
-
宿主:Rabbit
-
反應(yīng)種屬:Human, Mouse
-
免疫原:Recombinant Human Neurotensin/neuromedin N protein (24-143AA)
-
免疫原種屬:Homo sapiens (Human)
-
標(biāo)記方式:Non-conjugated
本頁面中的產(chǎn)品,NTS Antibody (CSB-PA016136HA01HU),的標(biāo)記方式是Non-conjugated。對于NTS Antibody,我們還提供其他標(biāo)記。見下表:
-
克隆類型:Polyclonal
-
抗體亞型:IgG
-
純化方式:>95%, Protein G purified
-
濃度:It differs from different batches. Please contact us to confirm it.
-
保存緩沖液:Preservative: 0.03% Proclin 300
Constituents: 50% Glycerol, 0.01M PBS, PH 7.4 -
產(chǎn)品提供形式:Liquid
-
應(yīng)用范圍:ELISA, WB, IHC
-
推薦稀釋比:
Application Recommended Dilution WB 1:1000-1:5000 IHC 1:200-1:500 -
Protocols:
-
儲存條件:Upon receipt, store at -20°C or -80°C. Avoid repeated freeze.
-
貨期:Basically, we can dispatch the products out in 1-3 working days after receiving your orders. Delivery time maybe differs from different purchasing way or location, please kindly consult your local distributors for specific delivery time.
-
用途:For Research Use Only. Not for use in diagnostic or therapeutic procedures.
相關(guān)產(chǎn)品
靶點詳情
-
功能:Neurotensin may play an endocrine or paracrine role in the regulation of fat metabolism. It causes contraction of smooth muscle.
-
基因功能參考文獻(xiàn):
- In the elderly population, proneurotensin independently predicts development of cardiovascular diseases in both genders, whereas it only predicts diabetes in women. PMID: 29546332
- Neurotensin plasma values differentiate healthy people from patients suffering from colonic pathologies such as adenomatous polyps and adenocarcinoma. PMID: 28560510
- NTS may be an important stimulus to promote hepatocellular carcinoma invasion and metastasis both in vitro and in vivo. PMID: 27611941
- Higher concentrations of proneurotensin are associated with a greater risk of incident cardiovascular events in the community. This association did not vary according to sex, baseline low-density lipoprotein, or sortilin receptor 1 genotype. PMID: 27312221
- sortilin is a PIP3 binding protein with binding likely to occur at the C-terminal neurotensin binding site, and is a competitor of neurotensin PMID: 27666481
- children with untreated coeliac disease have elevated peripheral pro-NT levels compared with disease controls. Pro-NT levels also seem to reflect more severe forms of active coeliac disease, indicating a potential role of NT in small intestinal inflammation. PMID: 27612962
- findings directly link NT with increased fat absorption and obesity and suggest that NT may provide a prognostic marker of future obesity and a potential target for prevention and treatment PMID: 27193687
- Although no measures for pain threshold, thermal instability or gastric motility were performed in our study participants, higher plasma NT levels were found in PWS children PMID: 25847417
- pretreatment of gastric cancer cells with NTR1 inhibitor SR48692 was shown to significantly inhibit the NT-mediated MMP-9 activity, cell invasion, and migration PMID: 25724188
- NTS/IL-8/CXCR1/STAT3 signaling is crucial for the maintenance of stem-like traits in glioblastoma stem cells . PMID: 25200966
- NTS/NTSR1 complex enhances breast tumor aggressiveness via EGFR/HER2/HER3 pathway. PMID: 25249538
- Neurotensin and its receptor NTSR1 causes EGFR, HER2 and HER3 over-expression and their autocrine/paracrine activation in lung adenocarcinomas, confirming responsiveness to erlotinib. PMID: 25249545
- indicate that neurotensin is a direct target of the Wnt/beta-catenin pathway and may be a mediator for neuroendocrine tumor cell growth PMID: 25098665
- The antimicrobial peptide neurotensin has activity against invasive microbes. PMID: 12074933
- Results show that both the neurotensin (NT) and the neurotensin 1 receptor hNTS1(321-344)fragment present a 3D structure in complex. PMID: 23140271
- NT production by keratinocytes may exert a paracrine effect on other skin cells, namely fibroblasts, macrophages, and dendritic cells for correct wound healing. PMID: 24198343
- These findings provide new insights into the potential therapeutic role of NT in chronic wounds, such as in DFU, characterized by a deficit in the migratory properties of cells and a chronic proinflammatory status. PMID: 24000330
- Neurotensin-mediated calcium signaling appears more sensitive to differentiation than ATP-mediated Ca(2+) signaling PMID: 23962427
- Nanoparticles exposing neurotensin tumor-specific drivers. PMID: 23436714
- Data indicate synchronous increase of neurotensin (NTS) and IL-8 in hepatocellular carcinoma (HCC) correlated with worse prognosis and shorten survival after surgery. PMID: 23418512
- Proneurotensin expression in the tumor tissues indicated that this precursor was produced by small cell lung carcinoma tumors and secreted into plasma as the tumors grew. PMID: 22825476
- a lineage of mature enteroendocrine cells have the ability to coexpress members of a group of functionally related peptides: CCK, secretin, GIP, GLP-1, PYY, and neurotensin PMID: 23064014
- NTSR2 was overexpressed, NTSR1 decreased, and neurotensin was not expressed in B cell leukemia patient's B-cells, as compared with healthy B cells. PMID: 23109725
- Neurotensin secretion is regulated by PI3 kinase p110 alpha and protein kinase B signaling pathways. PMID: 22700584
- Endothelin-converting enzyme-1 (ECE-1) degrades NT in acidic conditions, and its activity is crucial for NTR1 recycling. PMID: 22416137
- CD133(+) liver tumor-initiating cells promote tumor angiogenesis, growth, and self-renewal through neurotensin/interleukin-8/CXCL1 signaling. PMID: 21994122
- Neurotensin signaling activates microRNAs-21 and -155 and Akt, promotes tumor growth in mice, and is increased in human colon tumors. PMID: 21806946
- Neurotensin signaling induces intracellular alkalinization and interleukin-8 expression in human pancreatic cancer cells. PMID: 19393580
- determined the status of ERalpha and ERbeta in the myometrium and leiomyomas, atypical leiomyomas and leiomyosarcomas, concomitantly with the expression of NTS/NTS receptor 1 in these tumors PMID: 21623207
- Human, pig, and frog NT and [Gln(4)]NT and [D-Tyr(11)]NT adsorbed to the silver surface via the tyrosine ring, the oxygen atom of the deprotonated phenol group of Tyr(11), and the -CH(2)- unit(s), most probably of Tyr(11), Arg(9), and/or Leu(13). PMID: 21542591
- study found that inhibition of mTORC1 signaling by rapamycin, torin1, and shRNA-mediated knockdown enhances NT secretion by increasing NT gene expression in the endocrine cell line BON PMID: 21508335
- Expression of neurotensin and ghrelin systems are markedly altered in the temporal lobe of Alzheimer's disease patients, which may contribute to the severe cognitive deficit observed in this pathology. PMID: 20858966
- Results indicate that the counteraction of neurotensin and neurotensin receptor subtype-1 regulates the genesis and development of pancreatic carcinomas. PMID: 21272935
- NT acutely regulates D2 autoreceptor function and DA neuron excitability through PKC-mediated phosphorylation of the D2R, leading to heterologous receptor desensitization. PMID: 21233215
- IGF-1R activation represents a previously unrecognized key pathway involved in the mechanisms by which NT and NTR1 modulate colonic inflammation and inflammatory bowel disease. PMID: 21212273
- Data show that neurotensin- and NTSR1-positive mmunohistochemistry staining in 60.4% and 59.7% of lung adenocarcinomas, respectively. PMID: 20810387
- key regulatory elements in the promoter region that are involved in human NT/N (hNT/N) gene expression PMID: 21030593
- Neurotensin is increased in serum of young children with autistic disorder. PMID: 20731814
- The expression of NTS is identified as a prognostic marker in patients with malignant pleural mesothelioma. PMID: 19932148
- neurotensin /NTR1 signaling in pancreatic cancer cells seems to promote the induction of a metastatic phenotype, in contrast to its varying effects on tumor cell proliferation. PMID: 20138826
- The aim of this study was to provide an up-to-date review of the literature concerning the regulatory role of NT on the hypothalamic-anterior pituitary axons--REVIEW PMID: 19878995
- topography of its binding site to NT 1 receptor PMID: 11906607
- Neurotensin induces protein kinase C-dependent protein kinase D activation and DNA synthesis in human pancreatic carcinoma cell line PANC-1. PMID: 11912133
- role in counteracting apoptosis in breast cancer cells PMID: 12150975
- Neurotensin expressing neurons develop earlier than vasoactive intestinal polypeptide, vasopressin, and neuropeptide Y expressing neurons in the suprachiasmatic nucleus. (neurotensin) PMID: 12531461
- neurotensin has a role in chronic mitogen-activated protein kinase activation and cancer progression PMID: 14699144
- Analysis of the NTS genomic sequence revealed 2 intronic polymorphisms and 1 variant located in the 5' untranslated region (UTR). None of the observed variants co-segregated with RLS and no disease-associated polymorphisms were detected PMID: 14743366
- neurotensin secretion is mediated by protein kinase C-alpha/-delta and Rho/Rho kinase, and protein kinase D PMID: 15123666
- Transcription of NT in the mitochrondria of BON cells in response to pharmacologic manipulation. PMID: 15358593
- MARCKS-mediated neurotensin release occurs via protein kinase C-delta downstream of the Rho/ROK pathway PMID: 15623535
顯示更多
收起更多
-
亞細(xì)胞定位:Secreted. Cytoplasmic vesicle, secretory vesicle. Note=Packaged within secretory vesicles.
-
蛋白家族:Neurotensin family
-
數(shù)據(jù)庫鏈接:
Most popular with customers
-
-
YWHAB Recombinant Monoclonal Antibody
Applications: ELISA, WB, IHC, IF, FC
Species Reactivity: Human, Mouse, Rat
-
Phospho-YAP1 (S127) Recombinant Monoclonal Antibody
Applications: ELISA, WB, IHC
Species Reactivity: Human
-
-
-
-
-